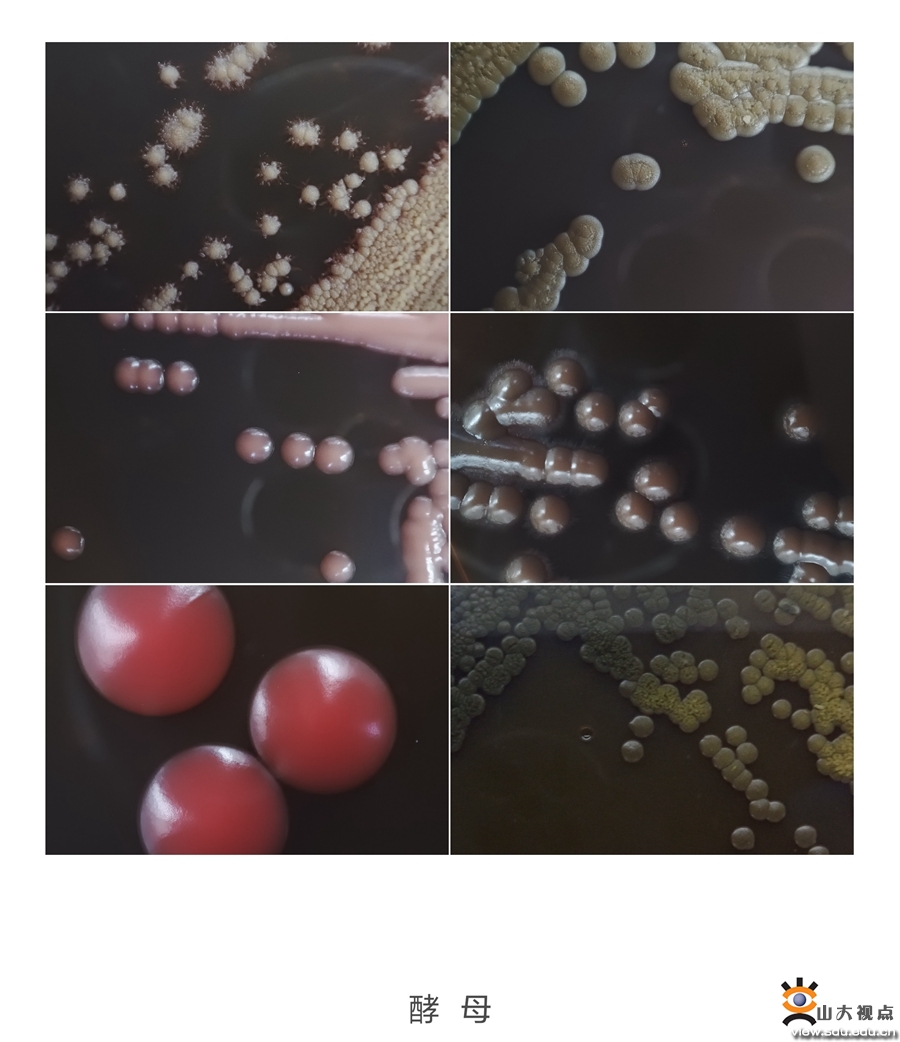
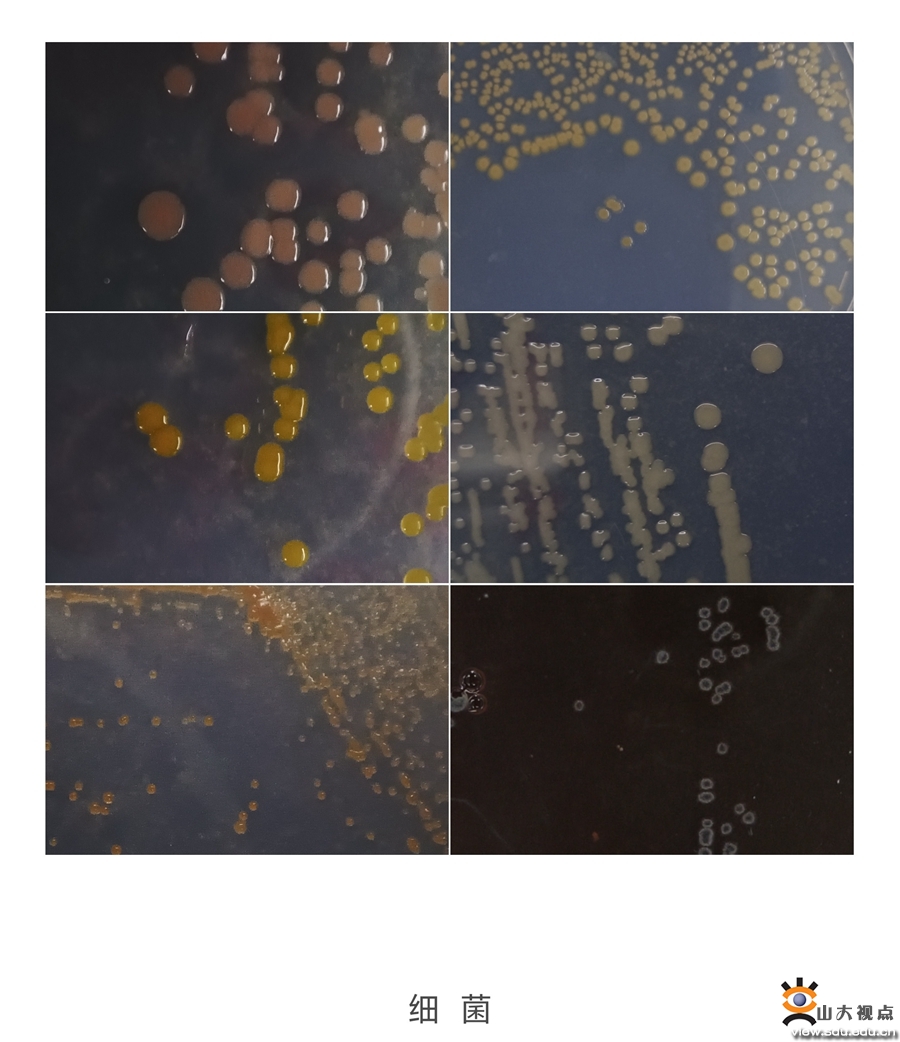
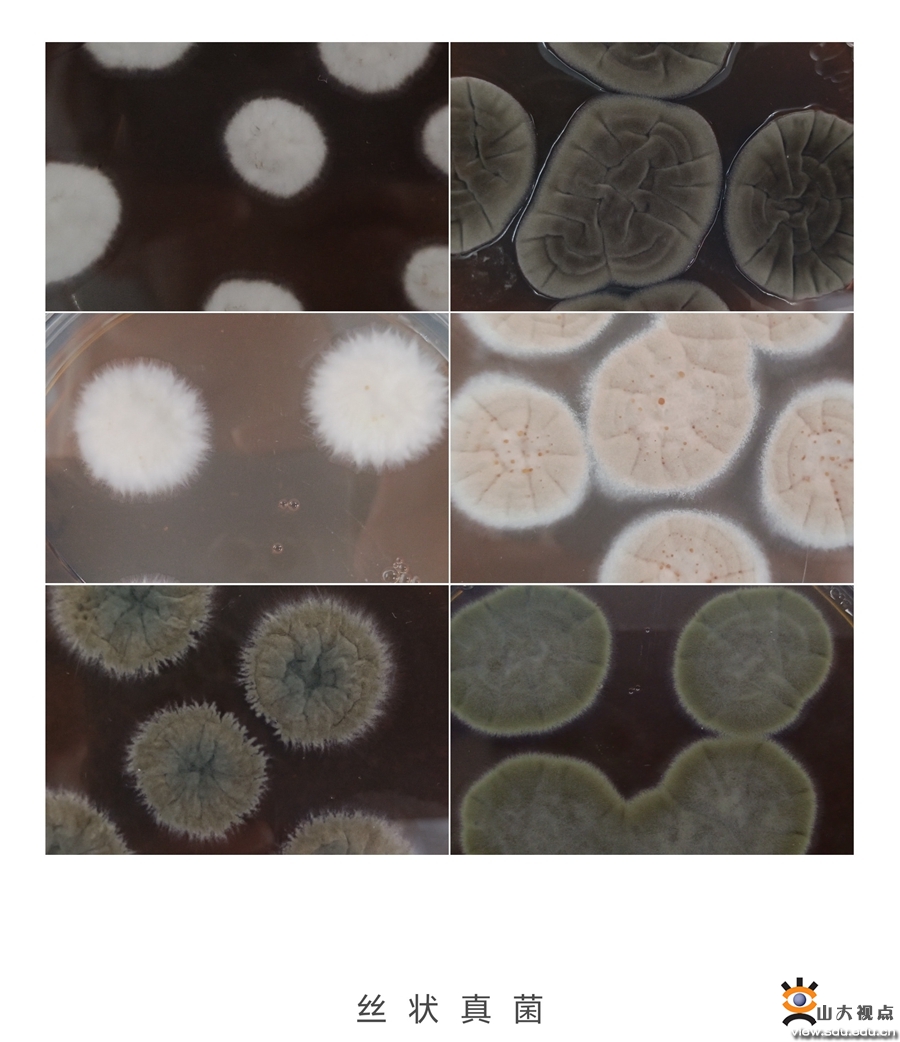

[本站讯]近日,搭载“蛟龙号”载人潜水器及全体科考队员的“深海一号”船胜利返回青岛国家深海基地码头,标志着本次中国大洋80航次第I航段顺利结束。山东大学微生物技术国家重点实验室(以下简称为“国重室”)刘怀伟和刘琨两位教师作为科考队员全程参与了本行段任务,这是山东大学以及国重室首次乘“蛟龙号”进行的远洋深潜考察。靠泊当日,国重室常务副主任李盛英专程赴青岛国家深海基地码头迎接两位教师凯旋。

此次航行于2023年6月16日从青岛出发,历时55天。

本次远洋科考是国重室与国家深海中心合作,在西太平洋进行深海的地质、生物多样性以及微生物资源调查工作。本航段以“大国重器”——“蛟龙号”载人深潜器作业为主,国重室两位老师先后搭乘“蛟龙号”进行深潜作业,其中刘琨在238潜次下潜5076米,刘怀伟在243潜次下潜2466米,均顺利完成深海海底精细观测与记录工作,并取回了宝贵的深海生物与沉积物样品。



此次是山东大学及国重室教师首次乘“蛟龙号”进行远洋深潜考察。

漫漫征途,收获颇丰。他们取回多种深海微生物样本。

在海上航行了将近两个月,如今凯旋,他们的征途中一定有许多难忘的经历,让我们来听听两位老师的感想与收获吧。
刘怀伟:行前未到夏至,归来已过立秋。历时55天的“中国大洋80航次科考”第I航段结束了。在这短短的55天里,我从I级海况里晕的起不来床的新手,迅速成长为了5米大浪里依然吃的香、睡得着的老队员;见证了蛟龙号“5天5潜”、“10天9潜”的新纪录。我有幸作为蛟龙号第110个潜航员,参与了第243潜次的科考任务;熟悉了“箱式”“CTD”“拖网”等多种采样器的工作流程;与以前在电视上见过的蛟龙队员们成为了朝夕相处的队友。当然、收获的不仅仅是技能的进步,也为国重室开展深海微生物研究提供了亟需的材料,这些都是让人感觉不舍的因素。短暂的航段虽然马上结束了,但大海永远在那里,深海一号也会在,期待下一次的相聚!

刘琨:非常荣幸能够参与国重室与国家深海中心的这次深入合作,作为科考队员参与“大洋80航次”,近2个月的远洋科考圆满完成任务并顺利返航,虽然现在已在陆地,但海上的工作生活经历将永远刻在心中。“深海一号”科考船装备先进,实验条件充备,60名船队员各司其职、分工明确、通力合作,展现出了卓越的团队精神,也让我体会到深海考察工作的不易。最难能可贵的是随“蛟龙号”下潜至深海5076.5米进行观察,切身感受到大国重器的先进及条件保障团队的专业。深海是亟待开发的生物资源宝库,深海海底丰富的微生物与基因库资源能为微生物相关研究提供宝贵的材料。远洋科考是人生的一种磨练,第一次出海结束了,而我与深海的故事才刚刚开始。
在不适合人类居住和作物生长的深海环境中探寻生命的痕迹,他们通过微生物的方式探索大洋深处的奥秘,不断挖掘深海微生物及基因库这座未被充分开发的资源宝库。接下来,国重室将深化与相关机构的合作,持续开展深海微生物及功能基因相关的科学研究,经略海洋、探索深海,为海洋强国战略提供有力支撑。
“蛟龙号”载人深潜器是我国首台自主设计、自主集成研制的作业型深海载人潜水器。2009年至2012年,“蛟龙号”接连取得1000米级、3000米级、5000米级和7000米级海试成功。2012年6月,在马里亚纳海沟创造了下潜7062米的中国载人深潜纪录,也是世界同类作业型潜水器最大下潜深度纪录,标志着我国深海潜水器成为海洋科学考察的前沿与制高点之一。“蛟龙号”可在占世界海洋面积99.8%的广阔海域中使用,对于我国开发利用深海的资源有着重要的意义。